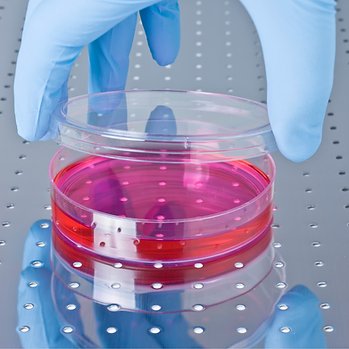

医師の学会が認めた歯髄幹細胞上清
当院では隆聖会labo.の歯髄幹細胞培養上清を使用しております。
医師の学会を母体とする臨床培養上清安全性審査委員会から、歯髄幹細胞培養上清は最高評価のAランクをいただいています。
今までエクソソーム療法で効果を感じなかった人ほど試してほしい製品です。
くつい歯科クリニックの歯髄エクソソーム療法をぜひ体感してください。
幹細胞培養上清とは?

幹細胞培養上清とは、幹細胞を培養増殖するために利用した培地の上澄みのことです。
幹細胞培養上清には、培養の際に幹細胞から放出されたサイトカインやエクソソーム、その他、500種類以上もの成長因子が多く含まれています。
これを利用することで従来の幹細胞移植に劣らない治癒効果が得られることが分かってきました。
それどころか細胞移植の危険性を回避できるため、安全な幹細胞治療として注目されています。
現在、幹細胞培養上清は、医療のあらゆる分野の様々な現場で用いられ、成果を上げ始めています。

圧倒的なエクソソーム量

ウイルスを用いて不死化処理された不死化細胞ではなく、純粋で新鮮な歯髄幹細胞を用いて作られた歯髄幹細胞培養上清は、既存製品の数倍から数十倍のエクソソーム量を誇ります。エクソソームの量だけでなく質にもこだわった上清だからこそ臨床の現場で結果が出るのです。
臨床医療品としての幹細胞培養上清
現在、培養が行われている間葉系幹細胞の多くは、脂肪、歯髄、臍帯血、骨髄、臍帯に由来します。
幹細胞培養上清、幹細胞培養液から、幹細胞を取り出しただけでは、臨床医療品として使えません。
培養増殖が完了した幹細胞を全て取り出した後に、幹細胞培養液を遠心分離し、不純物などを取り出し、ろ過、滅菌などいくつかの処理工程を行い、ウイルス検査に合格した製品が、医療品として認められます。したがって、幹細胞培養上清には、幹細胞自体は含まれていません。
臨床医療品として使用する幹細胞培養上清は、厚生労働省から認可された培養施設で作られた、安全性が高く、高品質な幹細胞培養上清を用いることが主です。
最近では、外服薬のみならず、品質の高いものは注射薬や点鼻薬、点眼薬としても使用されています。

幹細胞治療と幹細胞培養上清治療の違い
| 幹細胞治療 | 上清治療 | |
| 医学的リスク | 癌化/肺塞栓 | なし |
| 製造時間 | 長い培養時間 | 短い(ストックが可能) |
| 投与法 | 静脈投与 | 静脈投与 局所注入 経口 経皮など |
| コスト | 高い | 低い(安価) |
| 幹細胞治療 | 上清治療 | |
| 医学的リスク | 癌化/肺塞栓 | なし |
| 製造時間 | 長い培養時間 | 短い(ストックが可能) |
| 投与法 | 静脈投与 | 静脈投与 局所注入 経口 経皮など |
| コスト | 高い | 低い(安価) |
幹細胞治療も幹細胞培養液治療も、細胞を修復したり再生したりする点では同じですが、決定的に違う部分があります。
それは、幹細胞治療は、患者様自身の幹細胞を用いる細胞の移植であるのに対し、幹細胞培養上清は、細胞を用いない治療であるという点です。Cell Free(セルフリー)治療などとも呼ばれています。
細胞を用いないため、細胞の癌化や移植の際に起こりうる事故(肺塞栓:血管が詰まる)などの危険性がありません。それらが、培養上清が安全な幹細胞治療と呼ばれている理由です。
せっかく採取した自分の幹細胞が順調に培養できるとは限りません。細胞培養は難しい技術でもあります。そのため高い技術力を誇る施設で長時間かけて培養が行われるため多くのコストがかかり、治療費も高額になっています。
一方、上清を用いた治療はあらかじめストックすることができ、使いたいときにすぐ使えるという便利さがあります。当然コストも安いため、多くの方の手の届く幹細胞治療と言われています。
もちろん、幹細胞と同様に厳重に管理された培養施設で製造され、ウイルス検査をはじめ、安全性にも問題ない臨床医療品ですので、幹細胞治療と同様に、安心して治療を受けることができます。

歯髄幹細胞上清とは?
現在、培養が行われている間葉系幹細胞の多くは、脂肪、歯髄、臍帯血、骨髄、臍帯に由来します。
幹細胞培養上清、幹細胞培養液から、幹細胞を取り出しただけでは、臨床医療品として使えません。
培養増殖が完了した幹細胞を全て取り出した後に、幹細胞培養液を遠心分離し、不純物などを取り出し、ろ過、滅菌などいくつかの処理工程を行い、ウイルス検査に合格した製品が、医療品として認められます。したがって、幹細胞培養上清には、幹細胞自体は含まれていません。
臨床医療品として使用する幹細胞培養上清は、厚生労働省から認可された培養施設で作られた、安全性が高く、高品質な幹細胞培養上清を用いることが主です。
最近では、外服薬のみならず、品質の高いものは注射薬や点鼻薬、点眼薬としても使用されています。

培養上清の作り方

現在国内で入手可能な幹細胞上清は5種類といわれます。
① 脂肪由来
② 歯髄由来
③ 臍帯血由来
④ 骨髄由来
⑤ 臍帯由来
それぞれを比較した論文は乏しいのですが、歯髄由来幹細胞上清はほかの培養上清に比べて、特に以下の2つの特徴があるといわれています。
1)抗炎症作用
2)神経保護作用
歯髄由来幹細胞上清の特徴
POINT1
希少性が高い
1本の歯から得られる新鮮な歯髄幹細胞は、微量のため採取が難しい

POINT2
培養技術が高度
数個の細胞を数億まで増やす技術は難易度が高い
POINT3
遺伝子に傷がつきにくい
歯という固い組織がカプセルとなり、宇宙放射線などから細胞を守るため、他の幹細胞に比べると遺伝子に傷がつきにくい

POINT4
安全性の高い細胞
そもそも歯髄細胞は、がん化はもちろんのこと、良性の腫瘍すら無縁の安全性の高い細胞である

期待される効果・効能

花粉症

抗炎症作用
(アトピー性皮膚炎の改善)

創傷治癒作用
(傷跡の改善)

脳梗塞後の回復

たるみ・しわの改善

糖尿病

歯周病

関節炎

花粉症

抗炎症作用
(アトピー性皮膚炎の改善)

創傷治癒作用
(傷跡の改善)

脳梗塞後の回復

たるみ・しわの改善

糖尿病

歯周病

関節炎
エクソソーム歯ぐき注射の費用
エクソソーム注射
1㎖ 33,000円(税込)
- 料金は税込価格となります。
- 効果が感じられるまでは、3~4週間に1回をお勧めしています。
エクソソーム歯ぐき注射のQ&A
-
効果はどのくらいででますか?
-
個人差もあり、同じ方でもその時期のお体の調子でも差があります。
通常3~4回で体感を得る方、検査数値の改善がみられる方が多いです。
美容目的の方は初回から効果が感じられることが多いです。
-
どのくらいの間隔で注射を受けるのが効果的ですか?
-
効果が感じられるまでは、3~4週間に1回をお勧めしています。効果が出たら、維持のために2ヶ月に一度か3ヶ月に一度で継続されている方が多いです。
-
他院でがんの治療中ですが、培養上清の治療は受けられますか?
-
現時点で未治療の進行したがんをお持ちの方や、治療中の方に対する培養上清の注射は行っておりません。原則として、生活習慣病の予防、アンチエイジング、美容などを目的とした治療を行っております。また、がんの既往があっても根治した方であれば治療を受けられます。
-
何歳から受けられますか?
-
注射が可能なら年齢は問いません。
-
美容には脂肪幹細胞が良いと聞きましたが、歯髄でも効果がありますか?
-
歯髄幹細胞上清エクソソームは実は美容にとても効果があります。
抗炎症作用が際立って高いため、自分では気がつかない軽微な肌の炎症も抑えてくれるからです。また、肌環境を整えるという幹細胞特有の効果も期待できます。
-
歯髄よりも乳歯髄が良いと聞きますが。
-
日本のクリニックで用いられている乳歯髄や臍帯、脊髄、脂肪などの各種培養上清液の数倍から数十倍のエクソソーム量が、当院の歯髄幹細胞培養上清液には含まれています。
また、それが天然の純粋な歯髄幹細胞から作られているというのもこの製品の特徴です。
一般的にクリニックで用いられているのは、ウイルスを用いて不死化処理された幹細胞から作られた人工的な上清エクソソームです。
-
幹細胞に比べて上清エクソソームは効果が低いですか?
-
当院の歯髄幹細胞培養上清液は、幹細胞移植と変わらぬ効果を上げるために作られました。細胞移植と違い、上清エクソソームは複数回注射する必要がありますが、幹細胞移植と変わらない効果があると考えています。
